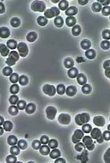
subject 12 after

| Shop Our Online Store: | ||
![]() Since 1980!
|
Momentum 98
Natural Health Store
Taking
Advantage of
the Moment!
Propelling Yourself into Greatness! |
3509 North High Street, Columbus, Ohio 43214 Email: moment98@gmail.com |

.
.
.
.
.
|
Quantum Age Water
Stirwands are one of the most exciting water discoveries of the 21st
century.
This is a new paradigm about water and its absorption into the human cell. This research, and discovery was inspired by the awarding of the 2003 nobel prize in chemistry to 2 scientists who clarified (in their research in 1988) how ions (from water or salts) are transported into the cells of the body by pointing out that the only way for a cell to absorb water is through aquaporin channels. Each cell has many of these protein channels through which water can be absorbed into the cell. The climax of their research was the discovery that since these protein aquaporin channels are so small, the only way water may enter into the cell in order to flush the toxins out, and to irrigate the cell is by entering ONE MOLECULE at a time. Now this research opened up an enormous opportunity to solve the larger problem of hydrating our cells. There is a widespread dehydration problem in the United States, and probably throughout the world. A man by the name of Exavier Phoenix has worked laboriously on a solution. In the mountains, water pours through rivers and streams, and many times we find pristine, pure sources of water which are not only very hydrating, and refreshing, but the water truly quenches our thirst. Famous water reservoirs such as Lourdes in France, and other water spots throughout the world have very healing properties. On the other hand, much of the water we drink in this country, whether it comes from springs, from processes such as PH ionizers, reverse osmosis, or from wells, distilled, or hundreds of other sources, still does not hydrate us sufficiently. Even waters with High PH, which is one of perhaps 8 factors involved in creating truly hydrating water, do not seem to hydrate us. What is the secret to hydrating ? We are told to drink half of our body weight in ounces of water each day, and still 94% of us are dehydrated. A great book, Your Body's Many Cries for Water, talks about the wonderful healing benefits that can be derived just by drinking water. This was written by a medical doctor who had been imprisoned in Iran dozens of years ago, and had no medicines to give the sick patients. He was able to assist hundreds of prisoners by administering water, and just water. The trick, it appears, is that the water he used was a very hydrated water. Hundreds of water products exist in the marketplace. We sell a number of them. Willard water appears to make water wetter. Many swear by its use. Alkalife increases the PH of the water you may wish to drink. They say that disease cannot exist in an alkaline situation, and consequently an acidic body harbors disease. There are hundreds of bottled waters out there. There are another hundred different formulas of water that one can take. You can use filtered water, crystallized water, ionized water, or distilled water. There is structured water, clustered water, water that is embodied with Love, as pointed out by Dr. Emoto in films, and in many of his books. All of these waters have merit. We embrace a number of these ideas. And none of them conflict with the Quantum Age Water Stirwands. Continue to use the best water you can. And THEN, place your Quantum Age Water Stirwand in your water (one glass to 1 gallon) for 20 seconds. In 20 seconds, SOMETHING, happens. I can do the best I can to explain what this is that happens. I suppose it is similar to the effect that the mountains have on mountain streams. The Ionic effect of the Rock in the Mountains, and the Water in the streams somehow creates a very hydrated water, that hence quenches a person's thirst. My belief is that it quenches a person's thirst because this water can be absorbed into the cells one molecule at a time, because the ionic effect somehow unclumps the water. Hydrogen (as in H20) is normally very unstable, and thus creates bonds with many of the other water molecules thus creating a clumping of tens and perhaps hundreds of water molecules. Somehow the rock in the mountains unclump these molecules, stabilizing the hydrogen atoms, creating a very hydrated water. We believe that the special blend of high matrix minerals that Exavier Phoenix discovered, has a similar effect on water. By placing the stirwand in water for 20 seconds, a miracle happens. The rocks or minerals encased in the surgical high-grade plastic never touches the water. Just as a lodestone or magnet can affect iron, somehow there appears to be an ionic exchange between these minerals and the water that somehow results in a very hydrated water. Hydration is dependent on many factors, including the PH of the water. Surface tension is important. So is the charge. Water is supposed to by definition, I believe, to have a specific gravity of 1.0000. For some reason most of your water has a specific gravity slightly higher, so I am told. And if the specific gravity is greater than 1.009, it is almost impossible for this water to be absorbed into the cell. Tap water was originally tested by Fenestra Research Labs to have a specific gravity of 1.023. After inserting the Quantum age water stirwand into this water for 20 seconds, the water was tested to have a specific gravity of 1.003. Now the water can hydrate a cell. Your body's experience is what is real. Your body can feel the difference. Similarly, if the surface tension of water is real high, or real low there is a problem in the water being absorbed by your cells. If the surface tension is really high, it makes the aquaporin channels of the cell tighter, and the water cannot get in. We have found that the stirwand adjusts the surface tension to give good cell integrity. The cell (with its inherent wisdom) will not absorb water if the surface tension would fall below a particular level. The natural electric charge of water can be measured in milliwatts and millivolts. High milliwatts is potential energy, and raises negative ions. This is what we want. High millivoltage is kinetic energy, which is active, and is damaging to the stability of the water. What we want is high milliwatt, and low millivolt. And this is exactly what this technology does. We have observed that by using the stirwand, the milliwattage is increased, and the millivoltage is decreased. In one particular test, water tested by Fenestra labs after a 20 second dip with the Quantum Age water stir wand registered a 11, 408 milliwatage charge, after originally having a milliwatt charge of 80. The millivoltage charge went from 232 millivolts to 136 millivolts after a 20 second insertion of the stirwand. Somehow, the Quantum Age Water Stirwand does something to the water to change its charge. The high matrix mineral combination in the stirwand does not even touch the water, but it can and does have an effect. Again, the analogy is: What does a magnet do ? It doesn't even have to touch iron and it creates some kind of draw. These above paragraphs are simply MY attempt to explain to myself and to you, or anyone else how or why the Quantum Age Water Stirwand works. But the important thing is that the explanation sort of doesn't really matter. Frankly, I do not understand how a TV works. Yes, I have a vague idea. But the important thing, is it does work, and I can benefit by turning it on. Similarly, I don't know necessarily how some herbs work, or how food works to energize me. I experience the benefits. Or in some cases, the non-benefits. But again, the Quantum Age Water Sitrwand has been shown to work in controlled laboratory experiences. Not in vitro, with rats, or in petri dishes, but with real human beings. Tests conducted by Fenestra Research Labs (see: www.fenestraresearch.com ) has conclusively shown what is on the poster on the top of this page. This is the scientific research that hundreds of doctors have asked for. Those doctors in alternative medicine, and those who are not. The quantum age water wand has gone through 3 separate human clinical trials. The 1st clinical trials tested 5 individuals, 2 using tap water, and 3 on purified water. Using the stirwand, regardless of the quality of the water, the average hydration increase was 23.5%. The 2nd research project tested 50 people over 30 days and found that those using the stirwand increased their hydration on the average of 23.5%, and increased their blood oxygen level an average of 9.6%. The 3rd human trial is a 3 month study, testing 100 people, 50 in a control group, and 50 using the stirwand. Using good drinking water, and each individual taking the recommended amount of water, the average increase in hydration after 30 days in the control group was 6.5%. For those using the stirwand, the average increase in hydration was 28.5%. Clinical Blood Microscopy shows before and after pictures of the blood of different subjects, as shown in the picture in the poster at the top of this page. After 7 days, the blood is now well-oxygenated, the blood platelets are NOT stuck together, and the blood is allowed to flow normally. Those who understand the scientific jargon can only be impressed. This is an incredible solution to the dehydration problem plaguing America. We invite you to go to our website and order this product for yourself. Quantum Age Water offers a 45 day money back guarantee, and we, Momentum98, stand behind this guarantee. There is a 5 year warranty on the product. We however, have every reason to believe that this product, this stirwand will last, 10,20, 30 perhaps even 100 years. A lodestone never loses its magnetic attraction. These high matrix minerals used in the base of the stirward should always have the same "ionic" effect on water it is placed in for 20 seconds. We have found that once water is charged for 20 seconds by the stirwand, you do NOT have to leave it in your water. You also do NOT have to stir the wand in the water. You can just set it in the water for 20 seconds. However, if the water is not drunk from an open container, you might like to place your stirwand into your container every couple of days, to make sure it still has the hydrating effect. (Fenestra Research labs has shown that the water will maintain 99% of its charge 48 hours later in an open container, and that a closed container will maintain 95% of its charge even after 60 days.) It all boils down to 3 things: Most people (about 90% of the people we have given "taste" tests to at shows or in our store) notice a difference in both taste, and texture. The comments are: The water is softer, silkier, velvetier (more velvety), lighter, fluffier, cloudier. Not so harsh, goes down quicker, goes to my head and shoulders, and not to my stomach, quenches my thirst, goes down lighter. Taste, Texture, and Quenching of Thirst. (3 things) We are talking about experience. These are ways that people experience hydration. Being hydration is wonderful. It's like feeling like you have a kid's body again. You are more spry. It is a pretty nice feeling. I could go on with ramifications of the effects of being hydrated. Suffice it to say that many illnesses will generally not and do not generally go away if you are constantly dehydrated. Let's use some imagery to express this. If your cells are dehydrated, and cannot absorb the water, you can have a dehydrated cell that looks like a prune, and the cell can be surrounded by all this water. The water is too clumped, and cannot be absorbed by the prune-look-a-like cells. The cells cannot get flushed of its waste products. There is no irrigation. How do you expect to get healthy if your cells can't take baths ? It's like the person in a row boat in the middle of an ocean. Water, water everywhere, and not a drop to drink. So let's unclump our water. Use the Quantum Age Water Stirwand, and watch (literally) miracles happen. We encourage all of you to take advantage of this opportunity. We expect all of you who use this stirwand will become healthier. If you are not well, we expect you to start feeling better and better. And if you feel pretty good, and really don't have any ailments, we expect you to start experiencing super-health, and a greater feeling of well-beingness. We guarantee you will be satisfied with your stirwand experience. And after you experience the 24-7 blue-violet stirwand that can be used 24 hours a day, 7 days a week, and experience a less stressed life, we feel you might like to try some of the other wands made with slightly different high matrix minerals which can give some other benefits as well. If your cells looked like prunes, do you think that you would NOT be stressed. And if we could make all of or most of your cells look like healthy plums instead of prunes, don't you think you would be a lot less stressed? Perhaps dehydration is a major cause of stress ? That is why we recommend the 24/7 blue violet Quantum Age Water Stirwand to everyone. Go to our web page: https://www.momentum98.com/quantum.html to see the benefits of the other 7 stirwands that are available to you. As the story unfolds, the original stirwand was the turquoise Olympian stirwand. Some people complained. They used the wand in the evening, and because of the great hydration they were experiencing, they couldn't get to sleep. Others complained that their $100 bottles of wind tasted awful. And there are humorous stories, too. In the literature, it says be careful about using this in beer, as it might sort of ruin the taste. Similarly this may be true for carbonated drinks like coke, etc. Others asked for other effects, like illuminating their minds or creativity, or opening up their hearts. So Exavier Phoenix experimented some more, and created 8 different wands after much research and much trial and error. We say experiment, have fun. Get the whole collection of all 8 stirwands. Again see our website: https://www.momentum98.com/quantum.html for special prices on the complete set. Again , 45-day money back satisfaction guarantee. It is interesting to note, that there have been some who have tried to duplicate the particular mineral combination and effects that these stirwands have. None seem to have been successful. The surgical grade plastic used in
making these stirwands cannot easily
be damaged.
That is why we have a 5 year warranty on the product. Again, we encourage you to take advantage of THIS MOMENT NOW. Do so, and Propel yourself into Greatness ! Thanks so much for reading this elaboration of mine. It comes from my heart. Sincerely, and with love, Phillip Anthony Wilson, president of Momentum98 |
| Momentum98 Home Page | Go to Top of Page | Submit an order! | Email us |
Read our terms and conditions of sale. |
|
Mix
and Match the 3 or more/6 or more!
|
||||||
|
CODE
|
PRODUCT
|
UNIT
|
PRICE
|
3 or more (each)
10% Off! |
6 or more (each)
15% Off! |
|
|
QAW01
|
Stirwand - The Basic
|
blue/violet
|
$89.95
|
$80.95
|
$76.50
|
|
|
QAW02
|
Stirwand - Olympian
|
turquoise
|
$89.95
|
$80.95
|
$76.50
|
|
|
QAW03
|
Stirwand - Zen Master
|
purple
|
$89.95
|
$80.95
|
$76.50
|
|
|
QAW04
|
Stirwand - Warm Heart
|
rose
|
$89.95
|
$80.95
|
$76.50
|
|
|
QAW05
|
Stirwand - Guardian
|
orange
|
$89.95
|
$80.95
|
$76.50
|
|
|
QAW06
|
Stirwand - Illuminator
|
yellow
|
$89.95
|
$80.95
|
$76.50
|
|
|
QAW07
|
Stirwand - Gardener
|
amber
|
$89.95
|
$80.95
|
$76.50
|
|
|
QAW08
|
Stirwand - Gourmet
|
clear
|
$89.95
|
$80.95
|
$76.50
|
|
|
QAW09
|
Stirwand - Set of 8
|
all 8 colors
|
$612
$719.60 reg price |
- |
-
|
|
| QAW11 | Stirwand Carrying Case
|
clear case |
$10.00 | $9.00 | $8.50 |